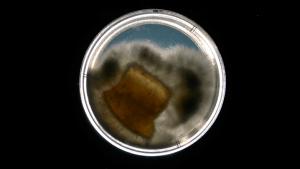

2018: co-elaborar mundos. Material vivo y laboratorios domesticos para hackear los circuitos materiales contemporaneos
Una de las preguntas en torno a las que se despliega el territorio delineado por el bioarte está ligada a los fenómenos de la vida. A partir de interrogar, por ejemplo, cuales son las configuraciones epocales de los sistemas vivos (¿Qué está siendo lo viviente?), el bioarte despliega vectores relacionales con una serie de campos de saberes y practicas: cs. exactas y naturales; poéticas filosóficas; narrativas contemporáneas; etc. En este contexto, la elección de un biomaterial es la elección de un partenaire de trabajo ¿Qué implicancias para la propia biografía y el territorio que configura un estudio-laboratorio artístico presenta el hecho de configurar una practica a partir de tiempos y comportamientos que no son los humanos? De esto se trató esta experiencias cuyas resonancias están más próximas a la performance que a las de las artes visuales en un sentido clásico.
Material utilizado: cultivo de reishi; sustrato compuesto por semillas y polvo de maderas; agua destilada.
En un primer momento, la experiencia consistió en indagar las posibilidades estructurales y compositivas del material; en un segundo momento, posibilidades expresivas. Una tercera etapa estará constituida por repensar la experiencia en el marco del bioarte y la performance.
Sobre el primer momento: es necesario deshacer cierta “ilusión de transparencia” respecto al espacio de trabajo, puesto que para generar el sustrato, la materia con la que se trabajará, es necesario montar un “laboratorio low tech” en el cual sea posible monitorear y controlar algunas variables (temperatura; luz; humedad, etc.). Es el “laboratorio” casero lo que hará posible el sostenimiento de la experiencia, solo dentro de él la experiencia tiene lugar. Por ello, parte de la obra/experiencia está ligada a la construcción de este espacio y sus instrumentos y performances ligadas a ellos: cámaras, recipientes de vidrio soplado creados especialmente para incubar y observar el crecimiento del biomaterial, mordería, etc. En este contexto el artista deviene científico y establece contactos con instrumental, practicas y discursos provenientes de otros campos ligados a la biología y las ciencias naturales.
Las fotografías que siguen refieren a los distintos momentos de la investigación. Concluye la serie con fotografías de objetos que refieren a un muestrario de objetos posibles que abren y desafíen el imaginario contemporáneo respecto a los materiales utilizados para la producción seriada de nuestro presente.
Cultivo
Duracion: 50 días.

Molderia modular
Colaboracion: Maria Egan (Diseñadora Industrial)
Lugar de elaboración: Tamaco / CheLa






Serie de contra-piezas
Duracion del proceso: 140 días










